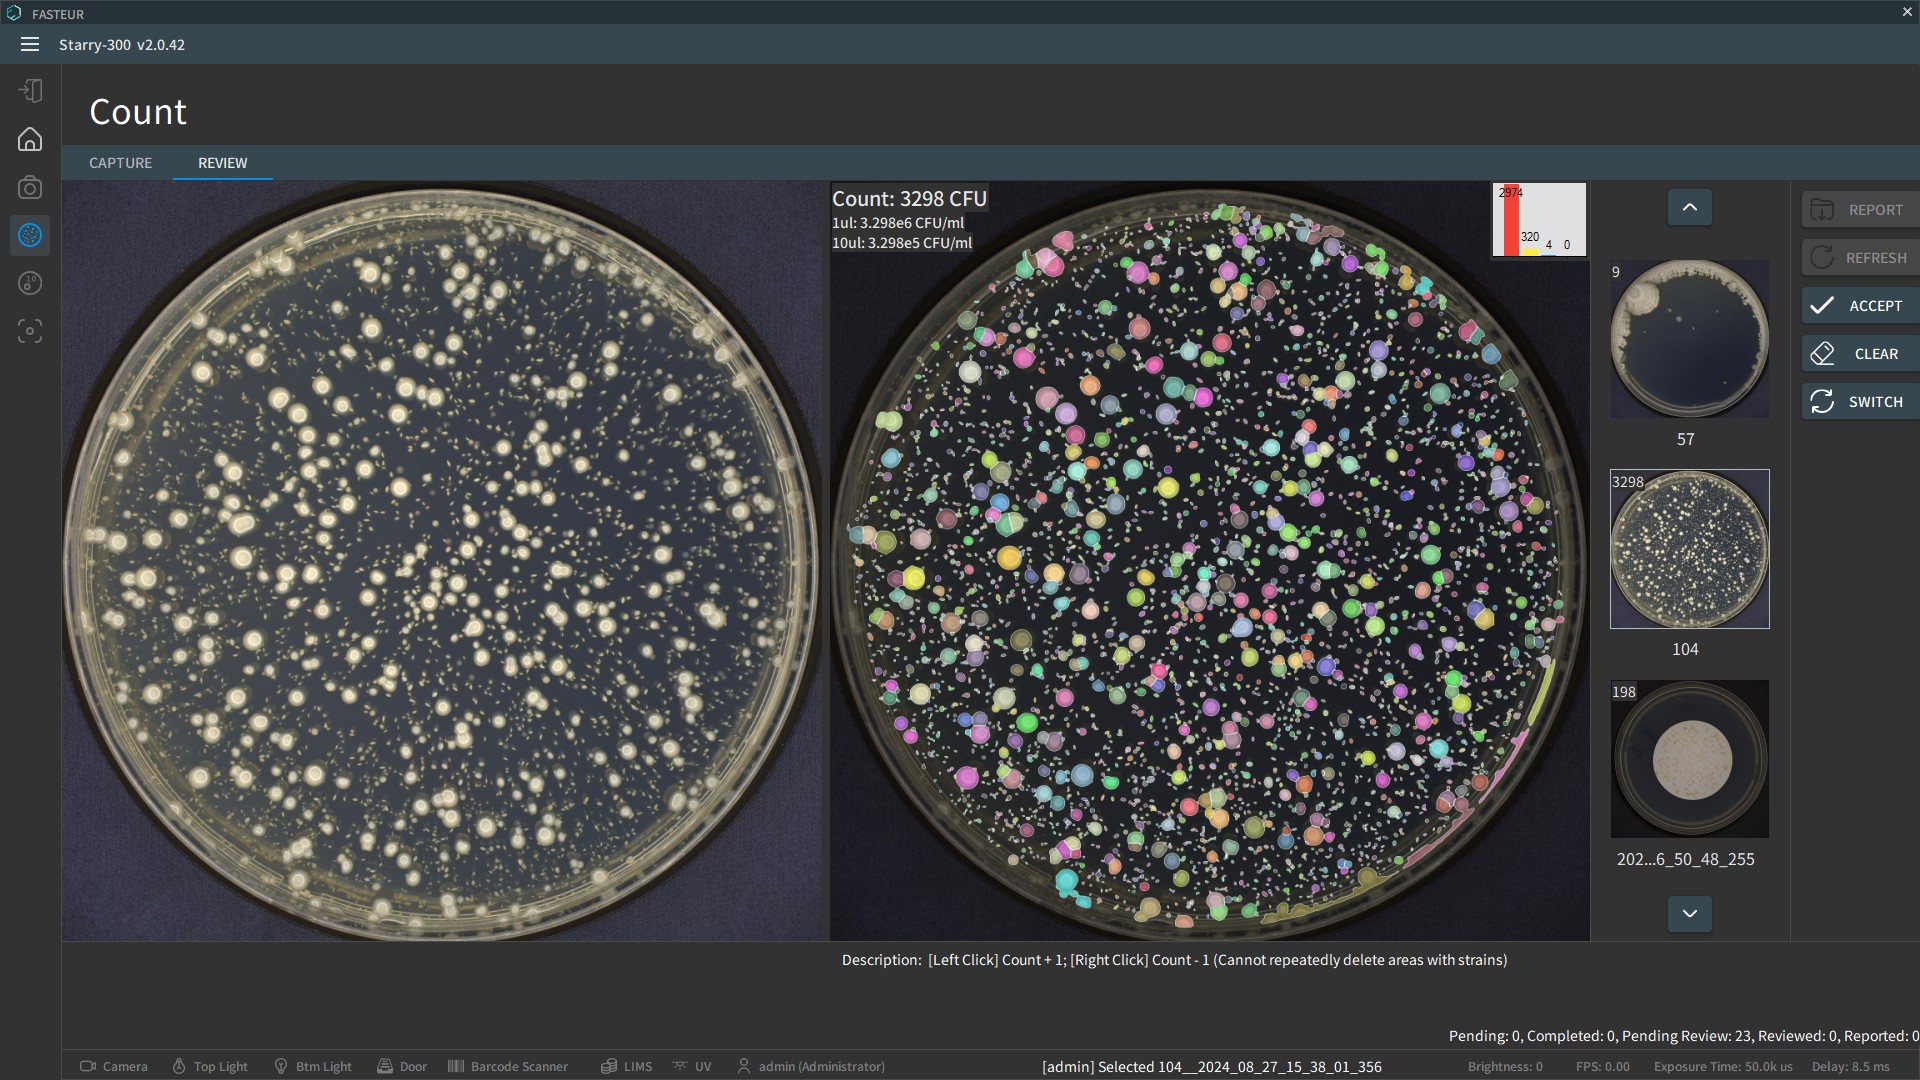
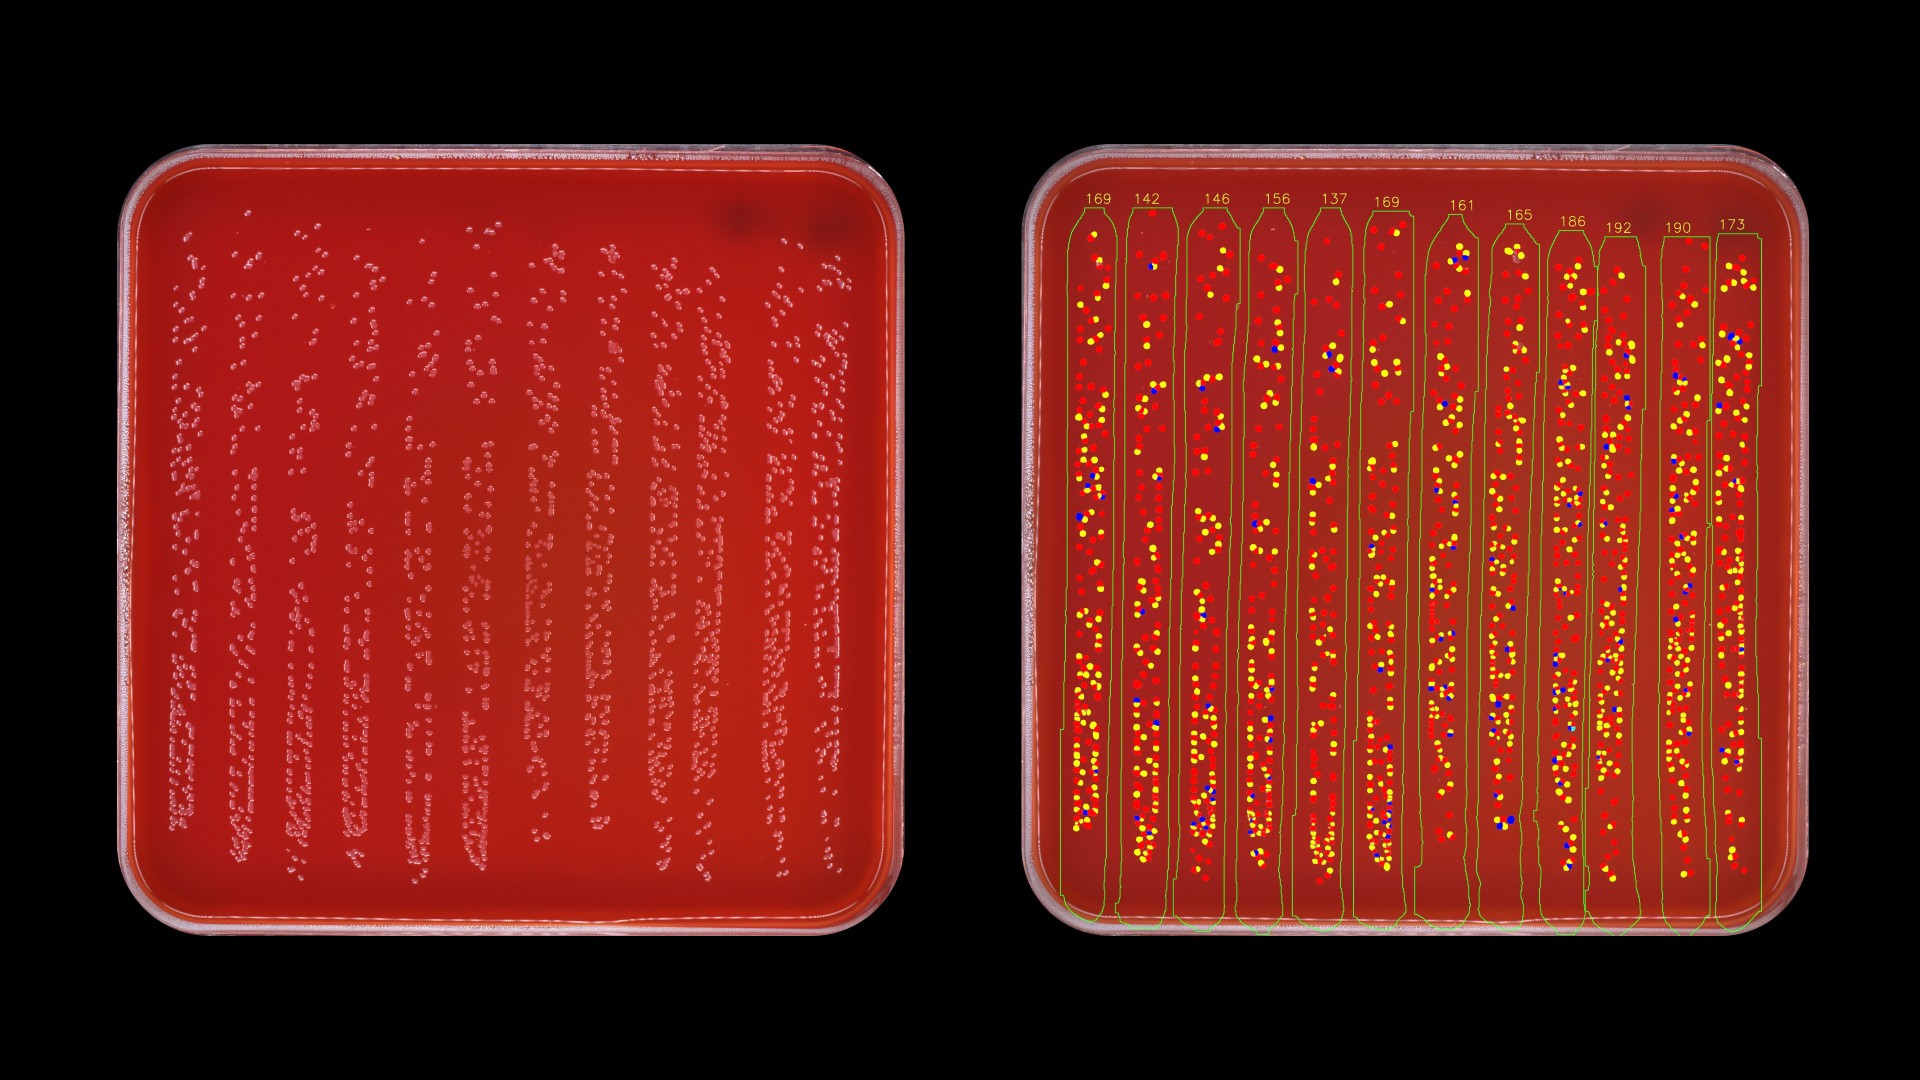
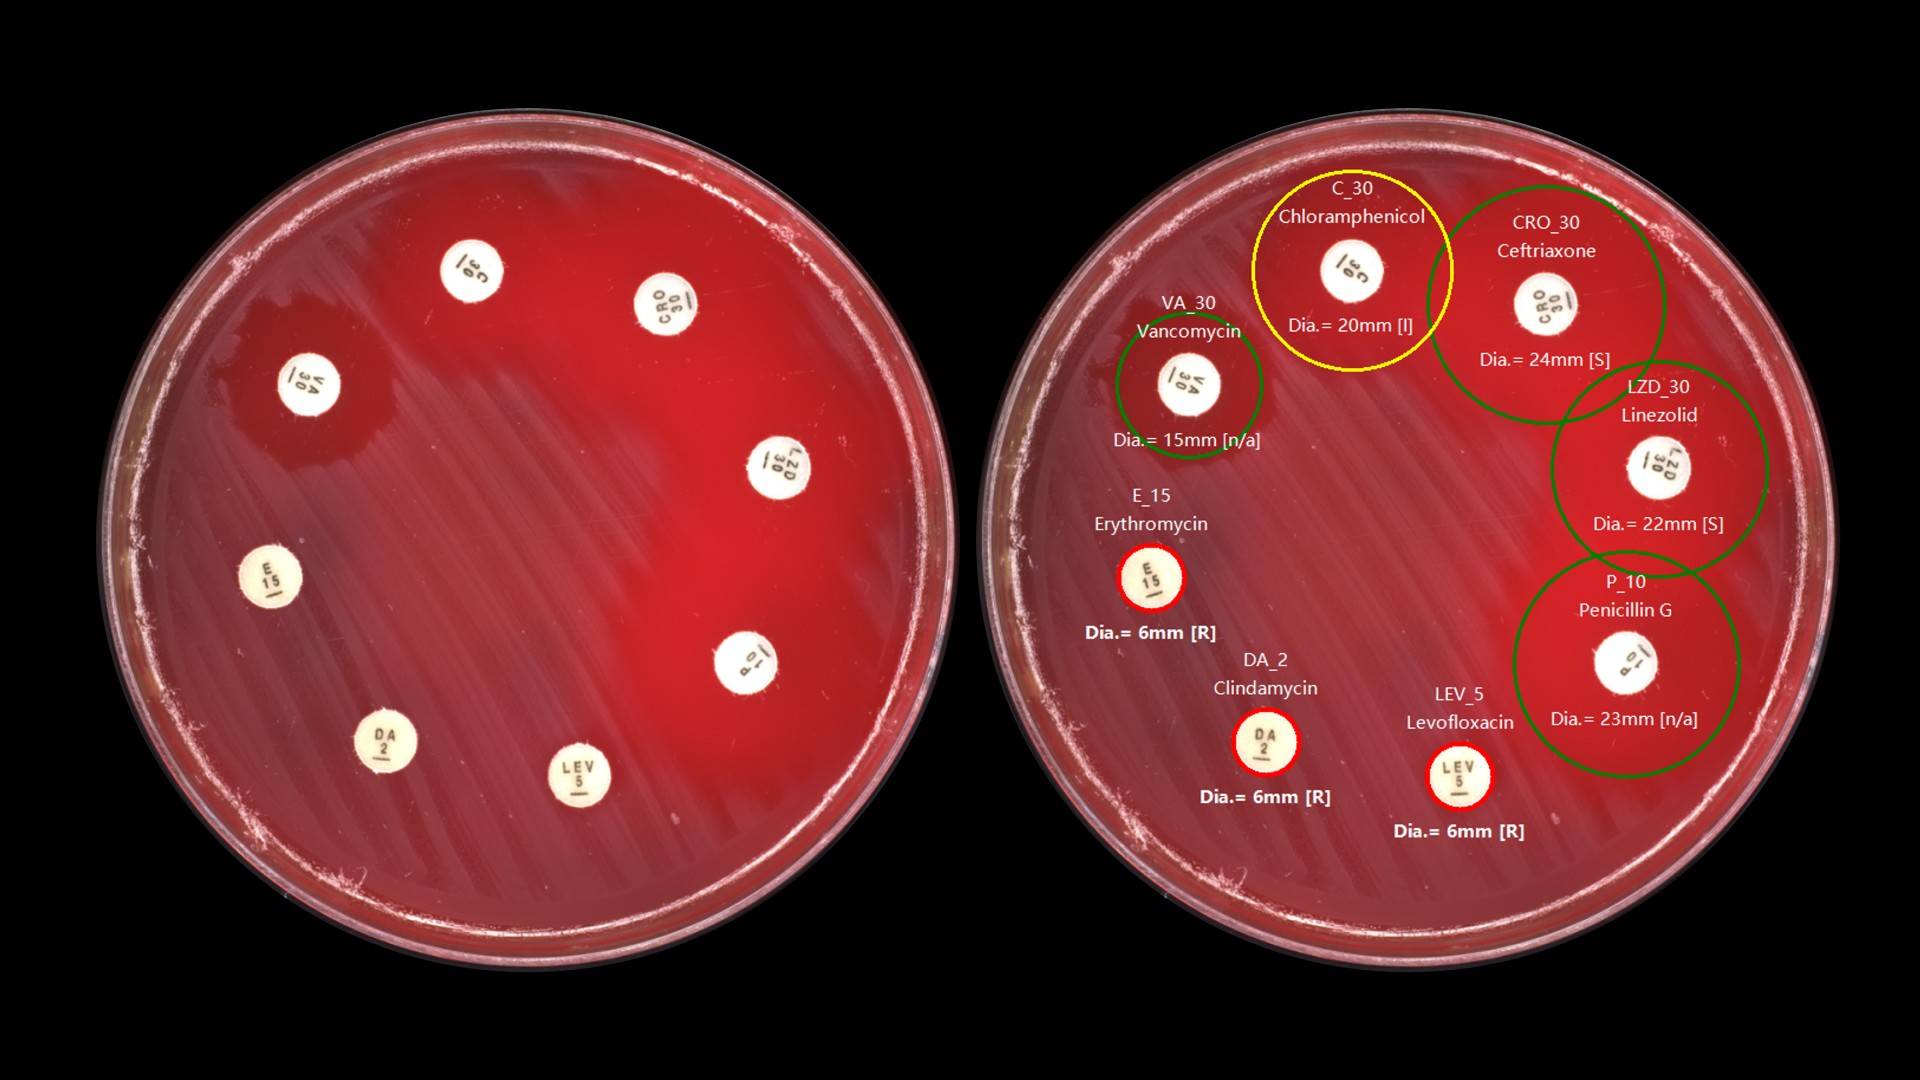
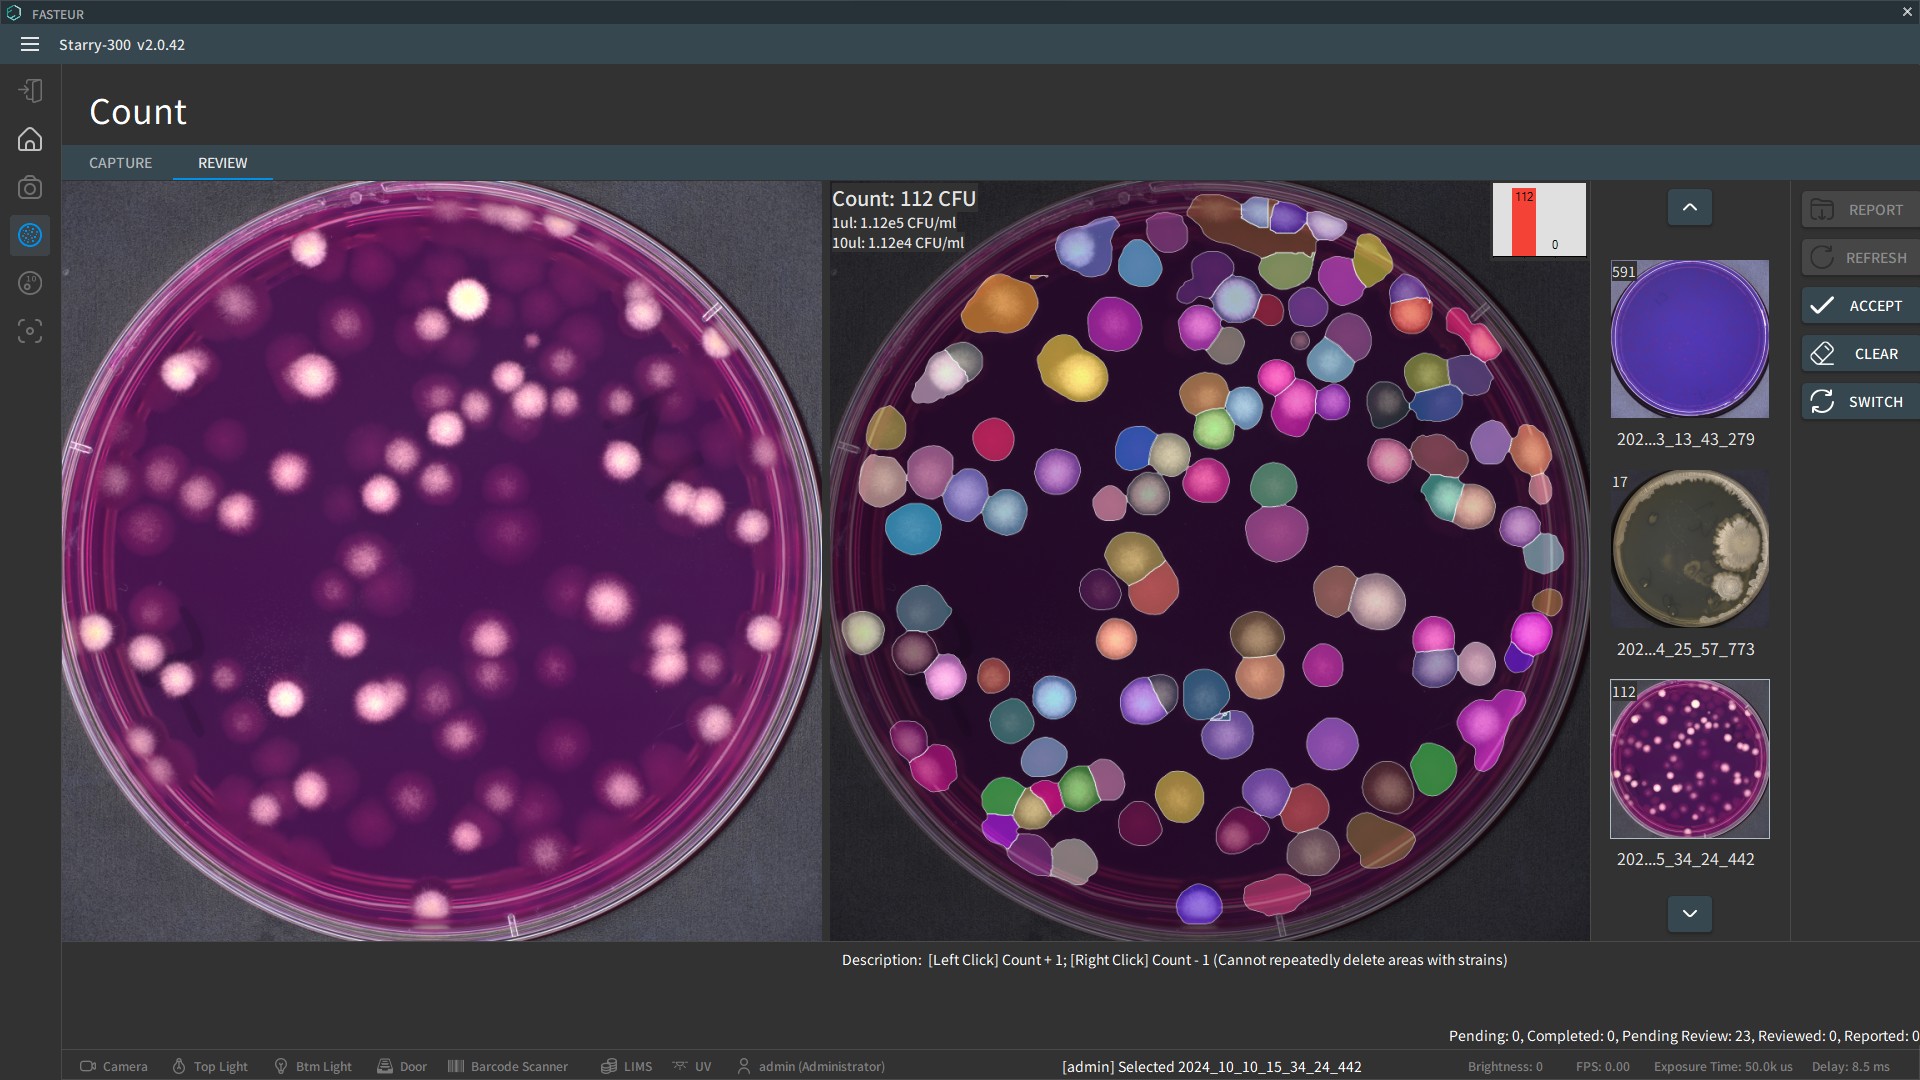
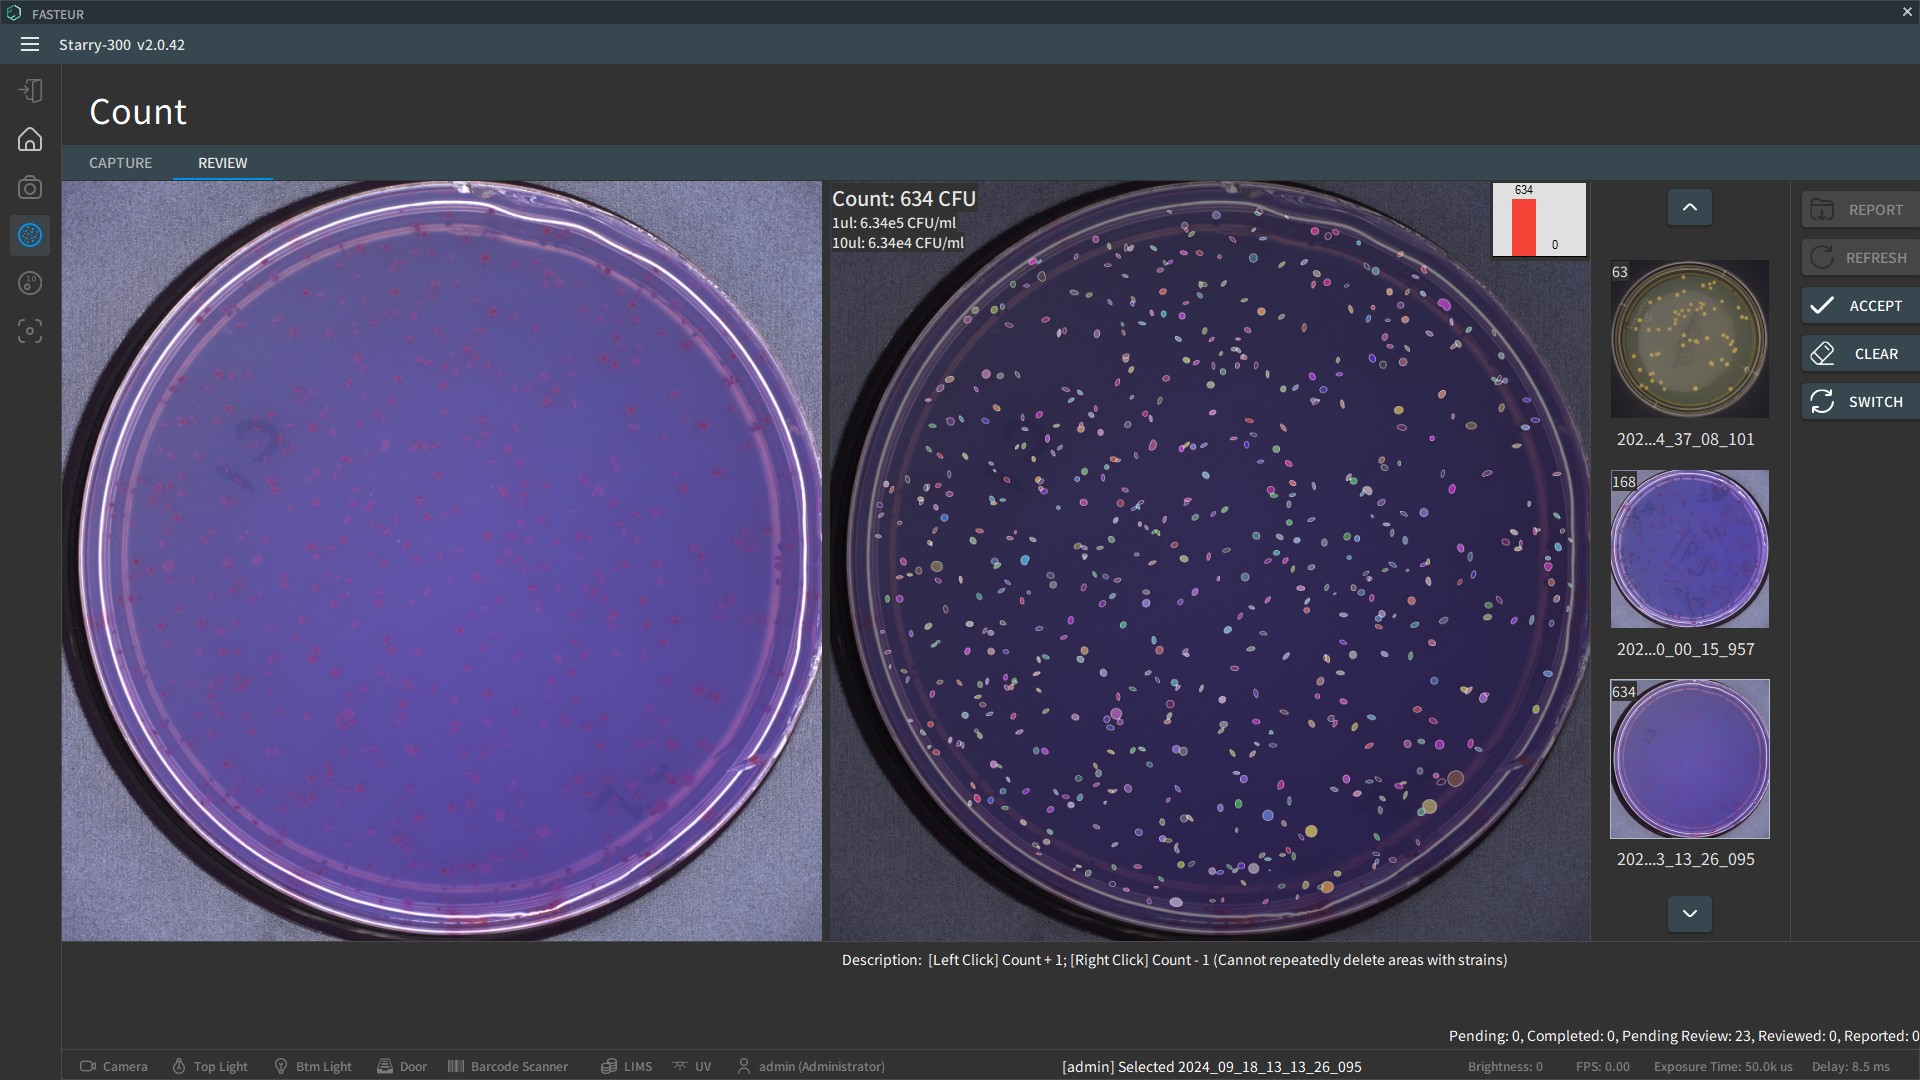
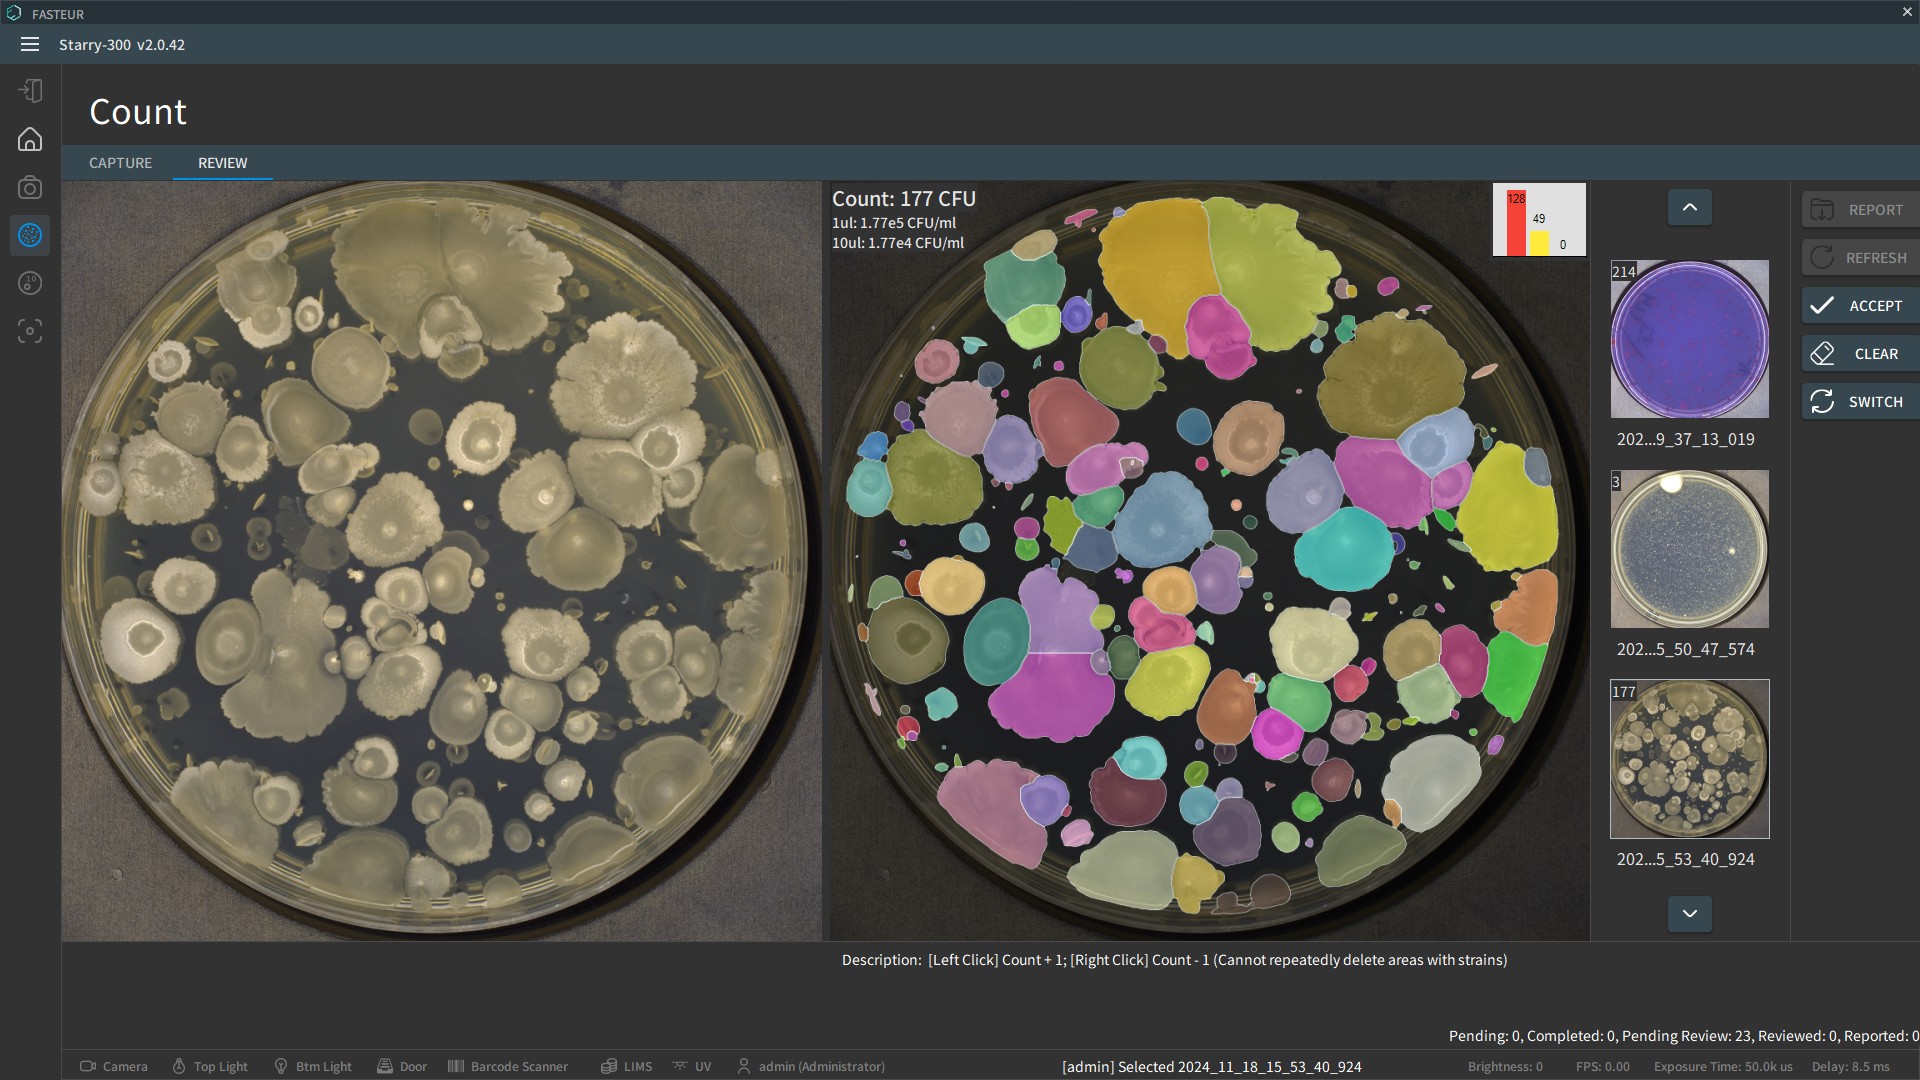
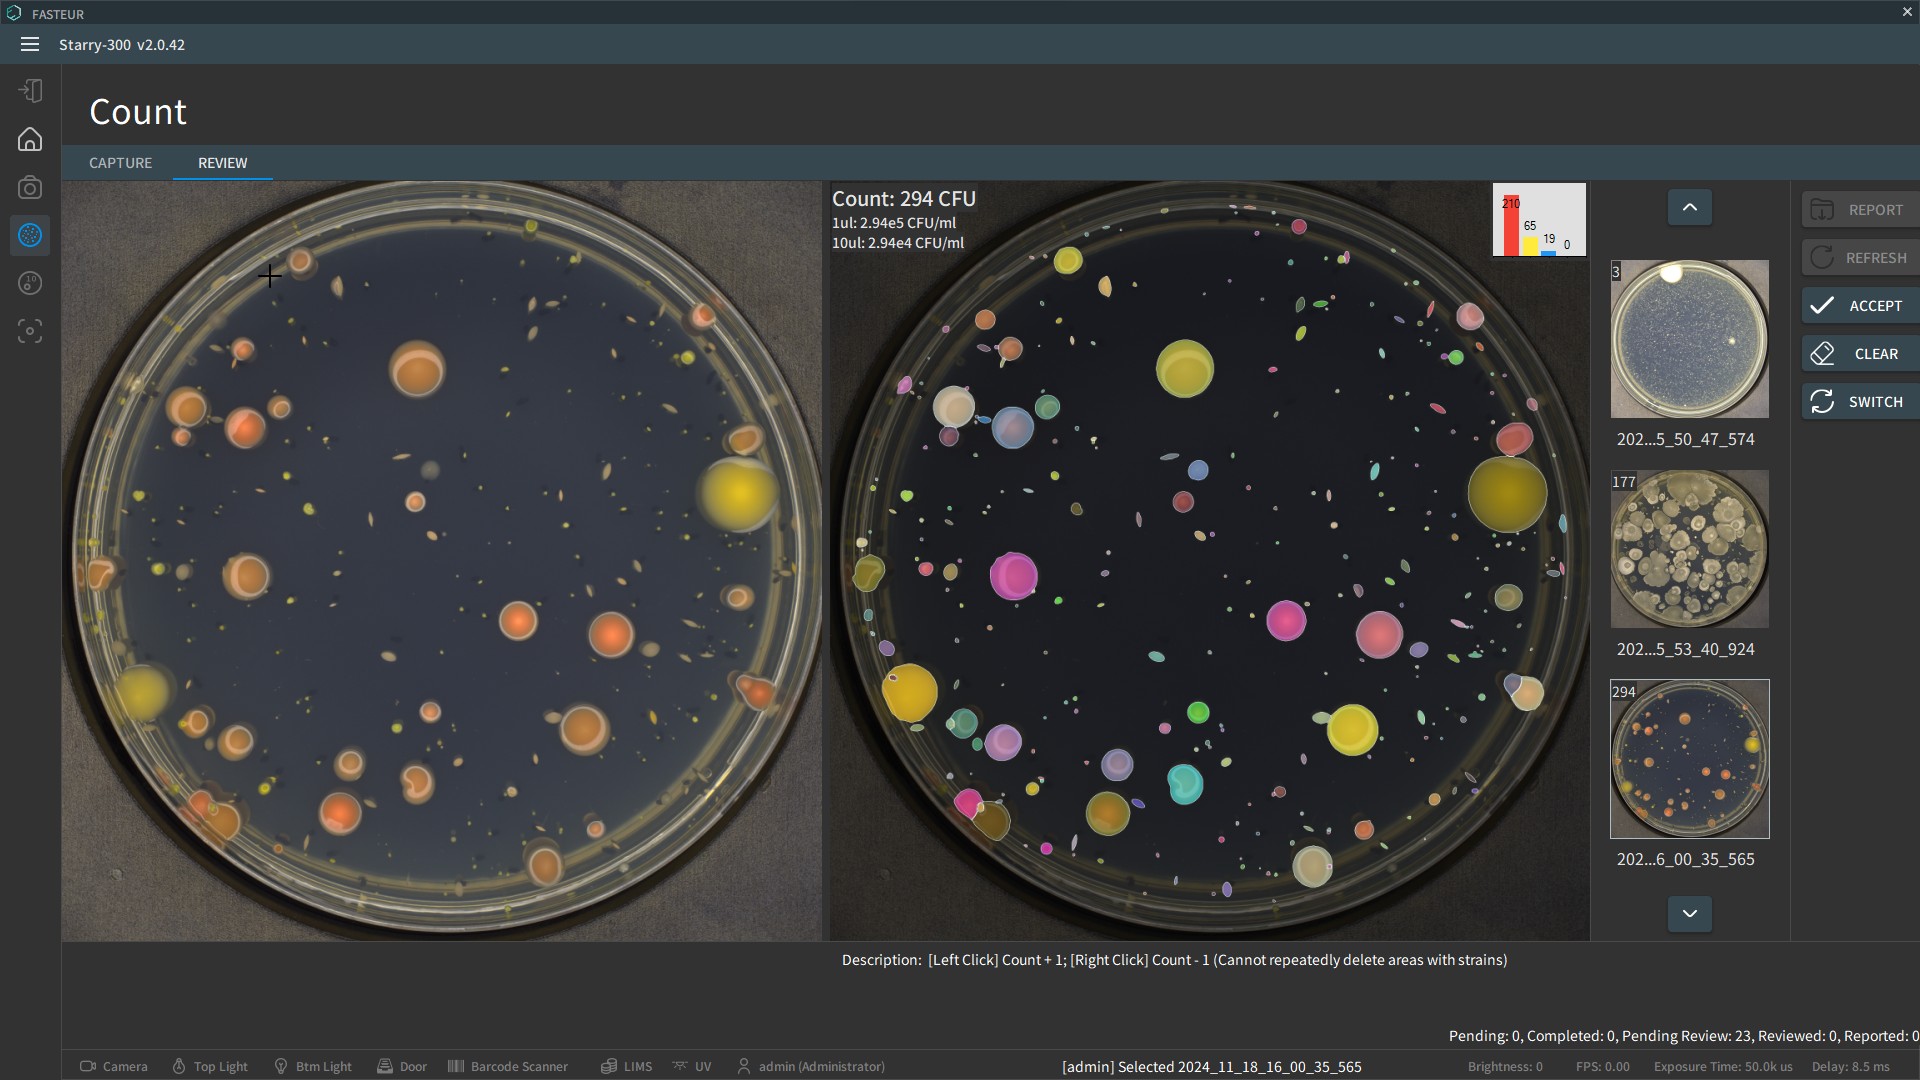

Morphology Details

20 MP Fusion Camera

Perfect Image
Equipped with a cutting-edge 20-megapixel camera and a lens resolution of up to 150 lp/mm, it captures unparalleled image detail. The system features high color rendering index LED-based dark-field and transmitted light sources, providing ultra-precise image data for AI training and delivering richly detailed colony morphology photos for our customers.
Find your photo
Powered by advanced AI, the Starry-300 automates every step, from exposure analysis to colony morphology assessment, ensuring seamless performance. Experience the ease of one-click operation, designed to save time and enhance productivity while delivering outstanding results.















AI Powered Versatile Solutions
for Healthcare, Pharmaceuticals, Environmental Monitoring, and Food Safety
Empowering Precision in Microbial Analysis with AI Innovation
Meet the Starry-300, your ultimate partner in revolutionizing microbial analysis. Powered by cutting-edge AI technology, the Starry-300 excels in colony identification, colony counting, antimicrobial susceptibility testing, and vaccine development, adapting seamlessly to diverse applications.
Unlock the future of microbial analysis—experience the Starry-300 and elevate your workflow to new heights!
From hospitals to pharmaceutical companies, environmental monitoring to food safety, the Starry-300 brings unparalleled precision and efficiency to every scenario. With its AI-driven automation, it eliminates manual bottlenecks, delivering faster, more reliable results while boosting productivity across the board.

Book now your demo
Discover the Starry-300 system in action! Experience its advanced AI-driven features, stunning imaging precision, and effortless one-click operation firsthand.
Book your demo now and see how it can revolutionize your workflow. Don’t wait—schedule your personalized demonstration today and unlock the future of colony morphology analysis!